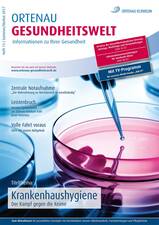
Ortenau Gesundheitswelt Ausgabe 13 / 2017

Ortenau Gesundheitswelt
Die Patientenzeitschrift des Ortenau Klinikums
Über 60.000 stationäre Patientinnen und Patienten versorgt das Ortenau Klinikum im Jahr mit erstklassigen medizinischen und pflegerischen Leistungen in seinen Fachkliniken und Zentren in Achern, Offenburg, Lahr und Wolfach.
Darin möchte Ihnen die Öffentlichkeitsarbeit des Fundraisings Ortenau Klinikum einen Einblick bieten: In ihrer halbjährlich erscheinenden Patientenzeitschrift „Ortenau Gesundheitswelt“ werden drei bis vier unserer vielen Fachkliniken mit ihren Chefärzten vorgestellt. Wir berichten über ausgewählte Erkrankungen, Diagnosen und Therapien.
Das stets aktuelle Heft erhalten Sie als Beilage der Sonntagszeitung Guller direkt nach Hause. Zudem liegt es in Ihren Arztpraxen und Apotheken aus sowie in unseren Kliniken für Patienten und Besucher, ebenso in Rathäusern der Gemeinden und Städte in der Ortenau. Auch dieses Angebot ist für Sie kostenfrei und ein wichtiger Beitrag zur Gesundheitsaufklärung.
Alle unsere Ausgaben finden Sie zum Herunterladen weiter unten auf dieser Seite.
Vorträge und Workshops rund um Ihre Gesundheit
Weitere Informationen zu den Veranstaltungen finden Sie in unserem Programmheft oder im Veranstaltungskalender.
Zum Veranstaltungskalender
Zum Programmheft
Zur Gesundheitsakademie Ortenau
Gutes tun - Ihre Spende hilft!
„Es kommt in der Welt vor allem auf die Helfer an – und auf die Helfer der Helfer.“
Albert Schweitzer, (1875 - 1965), deutsch-französischer Arzt, Theologe,
Musiker und Kulturphilosoph, Friedensnobelpreis 1952
OKapp - Patientenapp des Ortenau Klinikums
Laden Sie sich die App des Ortenau Klinikums herunter. In unserer OKapp haben Sie stets einen aktuellen Überblick über unsere Mitteilungen, so verpassen Sie künftig nichts mehr.
Ihr Ansprechpartner für:
Fragen zu den Spendenprojekten:
Dieter W. Schleier
Tel. 0781 472-8300
E-Mail: dieter.schleier(at)ortenau-klinikum.de
Fragen zu Spendenbescheinigungen und zum Genehmigungsverfahren:
Vera Bär
Geschäftsbereichsleitung Finanzen
Tel. 0781 472-4700
E-Mail: vera.baer(at)ortenau-klinikum.de